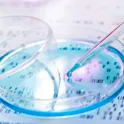

Health
10 May 2017
One step closer to finding out how wine may protect your neurons
Recent research, published in Frontiers in Nutrition, investigates the molecular mechanisms underlying the neuroprotective actions of wine.

Health
10 May 2017
Recent research, published in Frontiers in Nutrition, investigates the molecular mechanisms underlying the neuroprotective actions of wine.

Health
06 May 2017
Frontiers has published eBooks for the month of may, eBooks are open access research topics compiling articles in Science, Health & Engineering

Health
28 Apr 2017
Josep Bassaganya-Riera, a Frontiers Specialty Chief Editor and serial entrepreneur named 2017 Innovator of the Year by Roanoke- Blacksburg Technology Council (USA).

Health
28 Apr 2017
Frontiers in Immunology is honored to announce a memorial Research Topic dedicated to Dr William Erwin Paul and his unparalleled contribution to immunology.

Health
29 Mar 2017
Led by the new Specialty Chief Editor Prof. Yves Dauvilliers, this multidisciplinary section is open for submissions of studies on sleep, circadian rhythms and their disorders, including the clinical practice. We are happy to announce that Professor Yves Dauvilliers has joined Frontiers in Neurology and Frontiers in Psychiatry as the Specialty Chief Editor of the section “Sleep and Chronobiology”. “Sleep is a universal physiological need that plays a key role in the prevention of health problems. In modern life, sleep disruption through behavioral deprivation is a major issue”, says Prof. Dauvilliers in his Specialty Grand Challenge article. “Sleep disorders are very common and often disabling conditions that can be isolated or associated with neurological disorders. “ Prof. Dauvilliers is Head of the Sleep Laboratory at the University of Montpellier and the Director of the Sleep Disorders Centre, in the Department of Neurology at the Gui de Chauliac Hospital in Montpellier, in France. He is also the coordinator of the French National Reference Network for Orphan Diseases (Narcolepsy, Hypersomnia, Kleine-Levin Syndrome). You may find Professor Dauvilliers’ full biography here. Working on the diagnosis, epidemiology, pathophysiology and therapy of several sleep disorders, Prof. Dauvilliers has focused mainly on neurological disorders including narcolepsy but also […]

Health
24 Mar 2017
No subject pertains more to human life than nutrition. And no subject pertains more to science than methodology.
Health
15 Mar 2017
New section will focus on the use of gene editing in gene therapy, dealing with the ethical issues in the field, and making gene therapy more widely available.

Health
03 Mar 2017
Study shows how the effects of horseback riding improve learning in children.

Health
03 Mar 2017
Take a look at the Frontiers eBooks published in February 2017

Health
01 Mar 2017
We are pleased to announce the launch of our brand new section Psychopharmacology in Frontiers in Psychiatry.

Health
24 Feb 2017
Improving the academic training of healthcare professionals in human nutrition is necessary to fight malnutrition

Health
01 Feb 2017
Scientists revise the typical use of male rats and point to sex-differences that can drastically change how we approach obesity in females.

Health
10 Jan 2017
We are delighted to announce that Prof. Marc Struelens will be leading our new specialty section in Frontiers in Medicine and Frontiers in Public Health: Infectious Diseases – Surveillance, Prevention and Treatment. Given the intertwined nature of the public health and medical community when it comes to infectious diseases, we felt that a combined editorial board will best serve both communities to provide the highest quality peer review for our authors. A former president of the European Society for Clinical Microbiology and Infectious Diseases (ESCMID), Prof. Struelens is currently Chief Microbiologist at the European Centre for Disease Prevention and Control and Professor of Medical Microbiology at Universite Libre de Bruxelles. Prof. Struelens has extensive experience and publication record in microbiology, infectious diseases and public health. He has chaired the Belgian Infection Control Society and the European Study Group on Epidemiological Markers in addition to being a member of national and international advisory boards in the field of infectious diseases. Describing his vision for this specialty section, Prof. Struelens states: “I would like to provide a respected and interactive forum where medical researchers publish and contextualize research advances on determinants of human infections, at patient and population levels, and translate this knowledge into innovative […]

Health
04 Jan 2017
Scientists distinguish ‘overweight’ and ‘overfat’, the latter including normal-weight people with enough fat to impair health: Frontiers in Public Health

Health
22 Dec 2016
Extra vitamin D can restore good bacteria in the gut, according to a study in mice, giving hope in the fight against risk factors for diabetes and heart disease
Get the latest research updates, subscribe to our newsletter